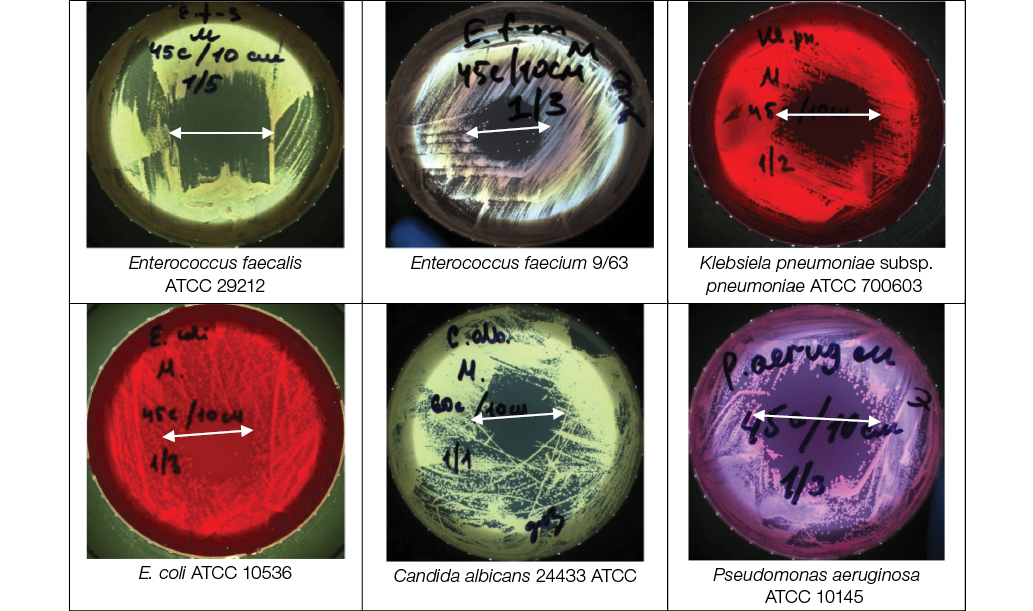

Scroll to:
Antimicrobial effect of low-temperature argon plasma on surgical infection in vitro
https://doi.org/10.47183/mes.2025-332
Abstract
Introduction. Low-temperature argon plasma (LTAP) has been widely studied as an alternative approach to prevention of purulent infections in cases of reduced germicide effectiveness due to the developed pathogen resistance.
Objective. Survival assessment of opportunistic pathogens under the action of LTAP exposure in in vitro models.
Materials and methods. The study was carried out using ESKAPE clinical strains (a “superbug” group with a high epidemic potential for the formation of hospital strains) and reference strains from culture collections, as well as strain mixtures. A PLASMORAN plasma arc unit (Russia) was used as a LTAP source. One plasma generation mode, three distance variants (from the nozzle to the Petri dish culture plane — 10, 15, and 20 cm), four LTAP exposure options (15, 30, 45 s for bacteria and 30, 45, and 60 s for fungi) were used. Pathogens survival after LTAP exposure in vitro was assessed by bacterial growth inhibition.
Results. LTAP showed a significant antimicrobial action against clinical strains of ESKAPE Gram-negative bacteria K. pneumoniae, R. aeruginosa, A. baumanii, E. coli, Gram-positive bacteria MRSA and yeast-like fungi C. albicans under an exposure duration of 30–45 s for bacteria (the required dose of UV-A radiation is 37.8 J/m 2 UV-B 15.9 J/m2 UV-C 34.2 J/m2) and a distance of 10–15 cm from the plasma generator nozzle. The antimicrobial effect is manifested in the absence of pathogen growth on culture media at the site of LTAP exposure at a certain exposure dose, duration, and distance. This effect ensures a decrease in the titer of viable microorganisms not only in monocultures, but also in bacterial associations, both in reference strains from culture collections and in ESKAPE clinical strains.
Conclusions. PLASMORAN-generated LTAP exhibits significant antibacterial and antifungal effects with respect to both reference strains from culture collections and ESKAPE clinical strains. The efficacy of LTAP action ensures a decrease in the titer of viable microorganisms from 10 8 –10 9 CFU to single CFU. The greatest effect of LTAP conditions (UV-A radiation dose of 37.8 J/m2; UV-B 15.9 J/m2; UV-C 34.2 J/m2) on bacterial cultures is observed under a distance of 10–15 cm and an exposure duration of 30–45 s. The optimal conditions for fungi (UV-A radiation dose of 168.6 J/m2; UV-B 68.4 J/m2; UV-C 159 J/m2) are a distance of 10 cm and an exposure duration of 60 s. Under standard dose, exposure duration, and distance, A. baumannii and E. faecium are more resistant to LTAP action than other studied bacteria. C. albicans is more resistant to LTAP action compared to bacteria, requiring a longer exposure and a shorter distance from the plasma generator nozzle to the treated surface. The results obtained require further study.
Keywords
For citations:
Zagainova A.V., Sukhina M.A., Zemlianoi A.B., Zelenina T.A., Markevich P.S., Novozhilov K.A., Fedets Z.E., Pankova M.N., Maniya T.R., Gritsyuk O.V. Antimicrobial effect of low-temperature argon plasma on surgical infection in vitro. Extreme Medicine. 2025;27(3):351-366. https://doi.org/10.47183/mes.2025-332
INTRODUCTION
Bacteria are ubiquitous inhabitants of the environment and the human body, which play a vital role in maintaining ecological balance. Among all known bacteria, including those without pathogenic potential, only about 1% can cause infections in patients with weakened immune systems. I. I. Mechnikov was the first to point out the possibility of normal human microflora to exhibit pathogenic properties. When skin damage occurs, both transient and resident opportunistic microflora can enter the wound surface. Opportunistic bacteria, such as Staphylococcus aureus, Streptococcus sp. and Pseudomonas aeruginosa, are common pathogens of skin and wound infections [1].
As a rule, antibacterial therapy is not aimed at infections caused by potentially pathogenic microflora due to widespread antimicrobial resistance [2–6]. Biofilms formed by attached bacteria further complicate the destruction of bacterial organisms [7–10]. In addition to the continuously extending list of drug-resistant microorganisms, antibacterial therapy is often inapplicable in patients with allergic and toxic drug reactions [11].
Growing antimicrobial resistance, which spreads globally, is a serious hazard to human health. In recent decades, the number of multidrug-resistant (MDR) bacteria isolated from the environment and biomaterials has increased, including Gram-negative bacteria Escherichia coli, Serratia coli, Proteus mirabilis, Pneumocystis pneumoniae, Pseudomonas aeruginosa, and Gram-positive methicillin-resistant Staphylococcus aureus (MRSA) [12].
To date, research studies into infections caused by potentially pathogenic microflora have largely focused on identifying chemicals that are effective against bacteria. However, alternative approaches to the prevention and treatment of purulent infections based on physical factors are increasingly attracting attention, which is particularly relevant in view of the decreasing efficacy of germicides due to the phenomenon of antimicrobial resistance. Among them, low-temperature argon plasma (LTAP) is a promising local treatment tool with a significant bactericidal effect [13–16].
LTAP is a stream of partially ionized neutral gas produced at atmospheric pressure and macroscopic temperature [17]. The plasma stream contains charged particles (electrons, ions, free radicals, excited molecules) and ultraviolet radiation [18][19]. The bactericidal effect of plasma is associated with the synergistic action of ionized elements and ultraviolet radiation, which leads to oxidative stress and bacterial DNA damage [20–23]. Therefore, LTAP has a significant antimicrobial potential.
Medical products and equipment are processed in three stages: disinfection, pre-sterilization cleaning, and sterilization. Reusable instruments, devices, and equipment are treated with mechanical, physical (thermal), chemical, or combined methods after every patient use. The mechanical method is based on wiping systems, when large-sized devices and instruments that do not come into contact with blood are treated with disinfectant wipes. The physical (thermal) method consists in heating in water at a temperature of 70–80°C, steam, or hot air (e.g., bed items are sterilized by steam under pressure; medical products made of glass, metals, and silicone rubber that are not contaminated with secretions are disinfected with 120°C air). The chemical method involves immersing the instruments in disinfectant containers. Physical and chemical disinfection methods can be used in combination, e.g., treating instruments in a cleaning solution simultaneously upon their heating. Non-thermal plasma can be effective for sterilizing medical equipment when thermal or chemical treatment is not suitable [13][24][25].
Low-temperature plasma has been reported to improve skin regeneration in cosmetology [26][27]. It also showed efficacy in wound healing and pain reduction after hemorrhoidectomy, including due to its significant bactericidal effect [28]. LTAP treatment accelerated regenerative processes and wound cleansing during the correction of late purulent-inflammatory complications of contouring using polyacrylamide gel [29]. In [30][31], the bactericidal effect of LTAP was observed for the first time, when treating contaminated dentin areas.
Due to its nonspecific and penetrating action, LTAP can reduce microbial contamination of tissues, ensuring local bactericidal effects on infected wounds and reducing wound inflammation. LTAP has a number of key advantages, including a high nonspecific bactericidal activity and a low potential for the development of resistance. In addition, LTAP is a promising method for treating acute and chronic wounds due to its relative simplicity, low cost, and a lack of special requirements for the treatment of wound surfaces.
This study is aimed at assessing the survival of opportunistic pathogens under the action of LTAP exposure in in vitro models.
MATERIALS AND METHODS
The study was carried out using the following ESKAPE clinical strains — Klebsiella pneumoniae, Pseudomonas aeruginosa, Acinetobacter baumannii, Escherichia coli, Gram-positive MRSA Staphylococcus aureus, Enterococcus faecalis, Enterococcus faecium with multidrug resistance (according to the European Committee on Antimicrobial Susceptibility Testing — EUCAST), yeast-like fungi Candida albicans, reference strains from culture collections E. coli ATCC 10536, K. pneumoniae subsp. pneumoniae ATCC 700603, Staphylococcus aureus 906, Pseudomonas aeruginosa ATCC 10145, Enterococcus faecalis ATCC 29212, Enterococcus faecium 9/63, fungi Candida albicans ATCC 24433.
The strains were taken from the culture collection of the Laboratory of Microbiology and Parasitology (Centre for Strategic Planning of the Federal medical and biological agency). The study was conducted using certified reference materials with confirmed biochemical properties grown on dense agarized media (quality control). Reference cultures were acquired from national and state collections. The cultures were stored in a culture collection in a cryoprotective environment in low-temperature freezers at a temperature of –70°C.
The following dense agarized nutrient media were used for the microbial culture: Endo medium for the cultivation of E. coli culture, K. pneumoniae, P. aeruginosa; yolk-salt agar for the cultivation of S. aureus; Enterococcus-agar for the cultivation of E. faecalis and E. faecium; Sabouraud Fluid Medium for the cultivation of C. albicans.
In the study, the dynamic range of the action of LTAP conditions on the survival of individual ESKAPE pathogens strains and strain mixtures was assessed.
The research methodology was as follows. Daily cultures of microbial strains were drip-applied onto the surface of Petri dishes with agarized medium (d = 90 mm) to form a continuous lawn at the rate of 100 µL per dish. In the suspension applied to the agarized medium surface, each microbe content was 4.5 McFarland Standard No, which corresponds to 9.0 × 108–1.2 × 109 CFU/mL. The microbe suspension was thoroughly rubbed with a spatula over the entire agar surface. Then, each dish with the introduced microorganism was treated using a PLASMORAN plasma arc surgical wound treatment unit (TS 9444-001-43009282-2015 manufactured by Plasmoprom, Russia) in a preset mode, setting the distance of 10, 15, and 20 cm (Factor L) and the exposure duration of 15, 30, and 45 s for bacteria and 30, 45, and 60 s for fungi (Factor T). In the study, one plasma generation mode, three options for the distance from the nozzle to the Petri dish culture plane, and four exposure options for the LTAP factors were used. To estimate the microbial titer used for inoculation in a bacterial suspension inoculum, a dilution method was used with inoculation on a Petri dish, followed by CFU growth counting on the agarized media surface.
The sectors of bacterial culture seeding within the exposure area, which was monitored by the illumination zone on the nutrient medium, were treated. Non-treated microbial crops were used as a control.
After the LTAP exposure, the culture dishes were placed in a thermostat for cultivation. The control group with microbial crops was also placed in a thermostat for further incubation.
The LTAP effect on microbial growth inhibition was assessed by the presence or absence of a lysis zone on the nutrient medium. The results were evaluated by measuring the diameter of the lysis zone delay and counting the number of grown clones of microorganisms in the lysis zone.
The culture dishes were incubated in a BD240 incubator (Binder, Germany) for 24–48 h at a temperature of (37 ± 1)°C for bacteria and at two temperature conditions (37 ± 1)°C and (26 ± 1)°C for fungi. After incubation, the grown colonies were counted in two ways: manually and using a Scan 1200 automatic colony counter (France). The purity of each culture was identified by mass spectrometry using a Microflex mass spectrometer with specialized software (Bruker Daltonik GmbH, Germany). Subsequently, the biomass of the grown bacterial colonies in the exponential growth phase was removed from the surface of two dishes surface.
The LTAP effect on the survival of ESKAPE pathogens was evaluated after (24 ± 2) h for bacteria and after (48 ± 2) h and 7 days for fungi.
The plasma generator was operated in the following modes: the gas-dynamic flow of the working gas; recombination radiation with a wide spectrum — from the vacuum ultraviolet to the near infrared range; argon gas with significant catalytic properties in reactions involving oxygen, nitrogen, and their compounds; ozone formed as a result of recombination radiation action on atmospheric oxygen.
When treating the dishes with LTAP radiation, the dishes of the main group were positioned such that the LTAP radiation illumination spot of the marginal region covered the central inoculation area (Fig. 1). In the control groups of all the tested pathogens, the culture dishes were not exposed to LTAP radiation.
During exposure, the B2 device mode was used at the values of the time factor (T) of 15, 30, and 45 s and the distance factor (L) of 10, 15, and 20 cm. The energy characteristics used to illuminate the dishes are shown in Table 1. Since the device measures energy illumination (also known as radiation intensity) in W/m2, the energy accumulation is expressed in J/m2, which is equal to W/m2 × radiation time (s). The LTAP radiation energy characteristics were measured by the manufacturer using a TKA-PKM 13 unit. The device is equipped with three sensors: UF-A (400–315 nm), UV-B (315–280 nm), and UV-B (280–200 nm).
The efficacy of LTAP exposure was assessed by calculating the percentage of bacterial and fungal death on the surface of control and experimental samples according to the formula:
Efficacy (%) = 100 – ( (ΣT × 100)/Сm), (1)
Сm — the mean number of bacteria in the initial suspension, equal to the ratio ∑С/N;
∑С — the sum of all colonies grown on the dishes in all replications;
N — replication number;
Тm — the mean number of bacteria grown on the dishes after 24–48 h of crop incubation is equal to the ratio ∑Т/n;
∑Т — the sum of all colonies grown on the dishes after 24–48 h of crops incubation in all replications;
n — the dish number (at least five for each test microorganism or a mixture of test microorganisms in accordance with EN ISO 11737-11) used for the study (the same for control and LTAP-treated Petri dishes with test microbes).
The criterion of antimicrobial activity against test microorganisms or a mixture of test microorganisms was considered to be a decrease in colony growth by at least 99.99% or complete inhibition of their growth. Viable colonies were estimated by counting the grown colonies of each type of microorganism on the surface of nutrient media in Petri dishes (using a biological microscope Leica DM6B-Z, in/n-243302670221503917, s/n-503838 with an integrated camera; magn. ×100).
Statistical processing of the research results was carried out using the Statistica 10.0 software package (StatSoft Inc., USA). The standard deviation and error were calculated based on the results on each of five dishes, and the Student’s t-test with the Bonferroni correction was applied, considering the distribution to be normal. The differences were considered statistically significant at p < 0.05.

Figure prepared by the authors
Fig. 1. Geometry of the illumination spot on the treated surface formed by recombination radiation of LTAP depending on the value of Factor L: 1 — the border of the central and regional areas; 2 — the outer boundary of the edge area
Table 1. Characteristics of the PLASMORAN plasma arc surgical unit used for treatment
|
UV type |
Factor T, s |
|||
|
15 |
30 |
45 |
60 |
|
|
Factor L = 10 cm |
||||
|
UV-А |
42.15 |
84.3 |
126.45 |
168.6 |
|
UV-В |
17.1 |
34.2 |
51.3 |
68.4 |
|
UV-С |
39.75 |
79.5 |
119.25 |
159 |
|
Factor L = 15 cm |
||||
|
UV-А |
18.9 |
37.8 |
56.7 |
75.6 |
|
UV-В |
7.95 |
15.9 |
23.85 |
31.8 |
|
UV-С |
17.1 |
34.2 |
51.3 |
68.4 |
|
Factor L = 20 cm |
||||
|
UV-А |
12.15 |
24.3 |
36.45 |
48.6 |
|
UV-В |
4.68 |
9.36 |
14.04 |
18.72 |
|
UV-С |
10.2 |
20.4 |
30.6 |
40.8 |
Table prepared by the authors using their own data
Note: radiation intensity measurement E (J/m2) ± 10%
RESULTS AND DISCUSSION
The first stage of the study was carried out using reference strains from culture collections in triplicate for each combination, including the distance and time of LTAP exposure.
When exposing reference strains from culture collections to LTAP (at different exposure distances and times), bacterial growth inhibition (efficacy 99.999–100%) was achieved against E. faecalis ATCC 29212, E. faecium 9/63, K. pneumoniae subsp. pneumoniae ATCC 700603, E. coli ATCC 10536, P. aeruginosa ATCC 10145, S. aureus 906; the corresponding data are presented in Table 2.
The effectiveness of bacterial growth inhibition at the level of 100% was achieved for Enterococcus faecalis at a distance of 10 cm after 15 s when exposed to a dose of UV-A 42.15 J/m2, a dose of UV-B 17.1 J/m2, and a dose of UV-C 39.75 J/m2. At the same time, bacterial growth inhibition when exposed to doses of UV-A 84.3 J/m2, UV-B 34.2 J/m2, and UV-C 79.5 J/m2 was achieved at an exposure duration of 30 s, and when exposed to UV-A 126.45 J/m2, UV-B 51.3 J/m2, and UV-C 119.25 J/m2 after 45 s. When treated at a distance of 15 cm, bacterial growth inhibition was achieved after 45 s when exposed to UV-A 56.7 J/m2, UV-B 23.85 J/m2, and UV-C 51.3 J/m2.
As a result of LTAP exposure of reference strains Klebsiela pneumoniae subsp. pneumoniae ATCC 700603, E. coli ATCC 10536, Enterococcus faecalis ATCC 29212, Enterococcus faecium 9/63, Pseudomonas aeruginosa ATCC 10145 for 45 s with a UV-B dose of 15.9 J/m2 and of Candida albicans 24433 ATCC for 60s with a dose of UV-B with 68.4 J/m2 at a distance of 10 cm, all these microorganisms showed the absence of growth in the area of directed LTAP exposure; the corresponding data are shown in Fig. 2.
In the study, the LTAP effects on dishes with ESKAPE cultures were studied: Gram-positive bacteria MRSA S. aureus, E. faecalis, E. faecium; Gram-negative bacteria K. pneumoniae, P. aeruginosa, A. baumannii, E. coli, as well as on yeast-like fungi C. albicans, using different exposure distances (from the plasma nozzle to the Petri dish cultures plane) and exposure duration; the results are shown in Figure 3.
The research found that the use of variable LTAP parameters (distance and duration) allowed the efficacy of 99.999–100% in the inhibition of bacterial growth to be achieved (Table 3).
Experiments on LTAP action were carried out in five replications for ESKAPE clinical strains K. pneumoniae, P. aeruginosa, A. baumannii, E. coli, Gram-positive bacteria MRSA S. aureus, E. faecalis, E. faecium with multiple drug resistance (according to the EUCAST), and in three replications for each combination of LTAP action on reference culture mixtures E. coli АТСС 10536, K. pneumoniae subsp. pneumoniae АТСС 700603, S. aureus 906, P. aeruginosa ATCC 10145, E. faecalis АТСС 29212, E. faecium 9/63.
When studying LTAP action on a mixture of reference strains from culture collections, the efficacy of 99.999% was achieved under variable parameters of distance and exposure duration. Survival was mainly observed for strains of K. pneumoniae subsp. pneumoniae ATCC 700603; viable colonies of P. aeruginosa ATCC 1014530, collection strains of E. coli ATCC 10536, S. aureus 906, E. faecalis ATCC 29212, E. faecium 9/63 were not detected (Table 4).
When evaluating LTAP effects on the survival of microbial clinical strain mixtures, a 99.997–99.999% efficacy was achieved compared with the initial inoculum level. After LTAP exposure, single colonies of clinical strains of K. pneumoniae and A. baumannii were found on the incubation dishes, while viable colonies of strains P. aeruginosa, E. coli, S. aureus, E. faecalis, E. faecium, Candida albicans were not found. The research results are presented in Table 5.
The antimicrobial action of LTAP is manifested in the death of bacterial cultures (Gram-positive and Gram-negative potentially pathogenic clinical strains of microorganisms with multiple drug resistance) and yeast fungi.
The study showed that 99.999% of microbial death occurs at the minimal exposure dose of UV-A 12.05 J/m2, UV-B 4.68 J/m2, UV-C 10.2 J/m2 — combination of LTAP factors indicated in Table 5. An increase in the distance leads to a decrease in the LTAP effect. Conversely, an increase in the duration exposure intensifies the LTAP effect. Thus, an optimal combination of distance and duration enables the total LTAP energy to be transferred to the microorganisms. This observation was confirmed in vitro on microbial cultures such as K. pneumoniae, A. baumannii, and fungi C. albicans. Exposure at longer distances (15–20 cm) over time periods (15 s for bacteria and 30 s for fungi) had no effect on these cultures.
The LTAP exposure parameters that induced microbial death depended on the microbial type, exposure duration, and exposure distance. An exponential dependence of the viable bacteria number (A. baumannii, K. pneumoniae, and fungi C. albicans) on the energy illumination value (due to the exposure distance and exposure duration) at which the bacteria died, was found. It is important to note that LTAP treatment of MRSA S. aureus and Р. aeruginоsа disrupted the microbial viability completely at all values of distance and time parameters.
When studying the action of LTAP in vitro on the microbial survival of reference cultures of E. coli ATCC 10536, K. pneumoniae subsp. pneumoniae ATCC 700603, S. aureus 906, P. aeruginosa ATCC 10145, E. faecalis ATCC 29212, E. faecium 9/63, fungi C. albicans ATCC 24433 and ESKAPE strains K. pneumoniae, P. aeruginosa, A. baumannii, E. coli, Gram-positive bacteria MRSA S. aureus, E. faecalis, E. faecium, with multiple drug resistance (according to the EUCAST), yeast-like fungi C. albicans, the PLASMORAN-generated LTAP ensured a decrease in the viable microbes titer from 108–109 to single CFU/mL, i.e., by 8–9 orders of magnitude, for both culture collection strains and clinical bacterial strains, with the efficacy ranging within 99.99–100%.
The literature has previously recognized the potential antibacterial effect of low-temperature plasma on ESKAPE pathogens [31]. In general, complete growth inhibition of unfixed ESKAPE pathogens when exposed to low-temperature plasma is achieved from 1 min to 3 h, depending on the device, type of discharge, output voltage, and other factors [31]. The most rapid growth inhibition of ESKAPE pathogens was described by Flynn et al. (2015) [32]. When using thermal plasma of atmospheric pressure, a rapid antibacterial effect was found against all ESKAPE pathogens in an unfixed (planktonic) growth form. Complete destruction of Enterobacter cloacae was achieved in 45 s, P. aeruginosa — in 60 s, E. faecium, K. pneumoniae and A. baumannii were completely inactivated within 120 s. S. aureus was the most stable, requiring a 240 s exposure to low-temperature plasma for its inactivation.
As a research result, a high efficacy of LTAP in experimental conditions was achieved with the proportion assessment of death of viable bacterial and fungal cultures. In the present study, almost complete destruction of viable cells of ESKAPE pathogen test cultures occurred during the LTAP exposure of 15 s, at a dose of UV-A 12.15 J/m2, UV-B 4.68 J/m2, and UV-C 10.2 J/m2 at a distance of 20 cm.
C. albicansyeast-like fungi were found to be more resistant to LTAP exposure compared to bacteria. Their destruction requires a longer exposure and a shorter distance from the nozzle to the treated surface, while the exposure efficacy is similar to that for bacteria, i.e., 99.99–100%.
A number of studies have shown that fungi are less sensitive to low-temperature plasma than bacteria [33]. However, the effect of low-temperature plasma in inactivating fungi depends on the fungus type, the gases supplied, the distance between the plasma device and the sample, and exposure duration [34][35]. Most studies have reported that non-thermal and low-temperature plasma can effectively inactivate Candida albicans yeast cells [34].
Some researchers emphasize that the exposure of strains to low-temperature plasma is associated with safety problems; namely, microorganisms that survive plasma exposure can be modified both genetically and phenotypically, representing danger to the environment. Thus, C. albicans that survived plasma treatment demonstrated genetic variability, although showing no significant changes in metabolism and drug susceptibility [35]. On the one hand, this indicates that low-temperature plasma treatment is associated with a low probability of the formation of genetically and phenotypically unfavorable strains [34, 35]; on the other, more experimental data is needed to solve the safety problem. Further studies in this direction should be conducted to assess the safety of LTAP exposure and the contribution of its main parameters to the antibacterial and proliferative effect for the treatment of postoperative wounds in in vivo models.
Table 2. Efficacy assessment of LTAP effect on the survival of reference strains from culture collections (%)
|
No. |
Pathogen |
LTAP exposure duration, s |
Distances from the nozzle to the Petri dish culture plane, cm |
Control, CFU/mL |
||
|
10 |
15 |
20 |
||||
|
Effectiveness assessment (%) |
||||||
|
1 |
Enterococcus faecalis АТСС 29212 |
15 |
100 |
99.999 |
99.999 |
2 × 107 |
|
30 |
100 |
99.999 |
99.999 |
|||
|
45 |
100 |
100 |
99.999 |
|||
|
2 |
Enterococcus faecium 9/63 |
15 |
99.999 |
99.999 |
99.999 |
1.5 × 107 |
|
30 |
99.999 |
99.999 |
99.999 |
|||
|
45 |
99.999 |
99.999 |
99.999 |
|||
|
3 |
Klebsiela pneumoniae subsp. pneumoniae АТСС 700603 |
15 |
99.999 |
99.999 |
99.999 |
3.5 × 109 |
|
30 |
99.999 |
99.999 |
99.999 |
|||
|
45 |
99.999 |
99.999 |
99.999 |
|||
|
4 |
Escherichia coli АТСС 10536 |
15 |
99.999 |
99.999 |
99.999 |
3.0 × 109 |
|
30 |
99.999 |
99.999 |
99.999 |
|||
|
45 |
99.999 |
99.999 |
99.999 |
|||
|
5 |
Pseudomonas aeruginosa ATCC 10145 |
15 |
99.999 |
99.999 |
99.999 |
2.5 × 109 |
|
30 |
99.999 |
99.999 |
99.999 |
|||
|
45 |
99.999 |
99.999 |
99.999 |
|||
|
6 |
Candida albicans 24433 АТСС |
15 |
99.999 |
99.995 |
99.95 |
1.2 × 107 |
|
30 |
99.999 |
99.995 |
99.995 |
|||
|
45 |
99.999 |
99.995 |
99.995 |
|||
|
7 |
Staphylococcus aureus 906 |
15 |
99.999 |
99.999 |
99.999 |
1 × 109 |
|
30 |
99.999 |
99.999 |
99.999 |
|||
|
45 |
99.999 |
99.999 |
99.999 |
|||
Table prepared by the authors using their own data
Photos taken by the authors
Fig. 2. Efficacy assessment of LTAP effect on the survival of reference strains from culture collections: the distance from the nozzle to the Petri dish culture plane is 10 cm, LTAP exposure duration — 45 s (60 s for Candida albicans АТСС 24433); the arrow indicates the area of bacterial growth inhibition




Photos taken by the authors
Fig. 3. Efficacy of LTAP action on the survival of ESKAPE clinical strains: the area of bacterial growth inhibition is indicated; magn. ×100
Table 3. Efficacy assessment of LTAP action on the survival of microbial strains
|
No. |
Pathogen |
LTAP exposure duration, s |
Distance from the nozzle to the Petri dish culture plane, cm |
Control, CFU/mL |
||
|
10 |
15 |
20 |
||||
|
Effectiveness assessment (%) |
||||||
|
1 |
Enterococcus faecalis |
15 |
99.999 |
99.999 |
99.999 |
1.4 × 108 |
|
30 |
99.999 |
99.999 |
99.999 |
|||
|
45 |
99.999 |
99.999 |
99.999 |
|||
|
2 |
Enterococcus faecium |
15 |
99.999 |
99.999 |
99.99 |
4.0 × 108 |
|
30 |
99.999 |
99.999 |
99.99 |
|||
|
45 |
99.999 |
99.999 |
99.999 |
|||
|
3 |
Klebsiela pneumoniae |
15 |
99.999 |
99.999 |
99.999 |
5.4 × 108 |
|
30 |
99.999 |
99.999 |
99.999 |
|||
|
45 |
99.999 |
99.999 |
99.999 |
|||
|
4 |
Escherichia coli |
15 |
99.999 |
99.999 |
99.999 |
4.0 × 108 |
|
30 |
99.999 |
99.999 |
99.999 |
|||
|
45 |
99.999 |
99.999 |
99.999 |
|||
|
5 |
Pseudomonas aeruginosa |
15 |
99.999 |
99.999 |
99.999 |
3.3 × 108 |
|
30 |
99.999 |
99.999 |
99.999 |
|||
|
45 |
99.999 |
99.999 |
99.999 |
|||
|
6 |
Acinetobacter baumanii |
15 |
99.999 |
99.99 |
99.99 |
1.5 × 108 |
|
30 |
99.999 |
99.999 |
99.99 |
|||
|
45 |
99.999 |
99.995 |
99.99 |
|||
|
7 |
Candida albicans Staphylococcus aureus |
15 |
100 |
99.99 |
99.99 |
1.0 × 107 |
|
30 |
99.999 |
99.999 |
99.99 |
|||
|
45 |
99.999 |
99.999 |
99.99 |
|||
|
8 |
Staphylococcus aureus |
15 |
99.999 |
99.998 |
– |
2.1 × 108 |
|
30 |
99.999 |
99.998 |
– |
|||
|
45 |
99.999 |
99.998 |
– |
|||
Table prepared by the authors using their own data
Table 4. Efficacy assessment of LTAP action on the survival of reference strains from culture collections
|
Exposure duration, s |
Exposure distance, cm |
Control, CFU/mL |
||
|
10 |
15 |
20 |
||
|
Efficacy, % |
||||
|
15 |
99.999 |
99.999 |
99.999 |
1 × 109 |
|
30 |
99.999 |
99.999 |
99.999 |
|
|
45 |
99.999 |
99.999 |
99.999 |
|
Table prepared by the authors using their own data
Table 5. Efficacy assessment of LTAP action on the survival of a mixture of microbial strains
|
Exposure duration, s |
Exposure distance, cm |
Control, CFU/mL |
||
|
10 |
15 |
20 |
||
|
Efficacy (%) |
||||
|
15 |
99.999 |
99.997 |
99.997 |
4 × 108 |
|
30 |
99.999 |
99.997 |
99.997 |
|
|
45 |
99.999 |
99.997 |
99.997 |
|
Table prepared by the authors using their own data
CONCLUSIONS
- PLASMORAN-generated LTAP was found to exhibit significant antibacterial and antifungal effects both against reference strains from culture collections and against ESKAPE clinical strains: K. pneumoniae, R. aeruginosa, A. baumannii, E. coli, Gram-positive bacteria MRSA S. aureusand E. faecalis, with multiple drug resistance (according to the EUCAST system), and yeast-like fungi C. albicans. The efficacy of LTAP exposure is manifested in the decreased titer of viable microorganisms from 108–109CFU to single CFU, i.e., by 8–9 orders of magnitude for bacteria, ranging within 99.999–100%.
- A. baumannii and E. faecium are more resistant to LTAP exposure than other bacteria studied.
- C. albicans is more resistant to LTAP exposure compared to bacteria, and their destruction requires a longer exposure duration and a shorter distance from the plasma nozzle to the treated surface, with an impact efficiency ranging 99.99–100%.
- The greatest effect of LTAP exposure is achieved when treating potentially pathogenic microorganisms at a distance of 10–15 cm and an exposure duration of 30–45 s for bacteria (the required dose of UV radiation is 37.8 J/m2UV-B 15.9 J/m2UV-C 34.2 J/m2) and at a distance of 10 cm and exposure time 60 s for fungi (the required radiation dose is UV-A 168.6 J/m2 UV-B 68.4 J/m2 UV-C 159 J/m2).
- Exposure to PLASMORAN-generated LTAP ensures a decrease in the viable microbial titer not only in monospecies culture, but also in the bacterial association both in relation to museum reference cultures and in relation to ESKAPE clinical strains K. pneumoniae, R. aeruginosa, A. baumannii, E. coli, Gram-positive bacteria MRSA S. aureusand E. faecalis, which have multidrug resistance.
- The use of LTAP for treating wounds is of great relevance for the prevention of purulent complications in surgical departments, including at the stages of evacuation of the wounded during military operations.
1 GOST ISO 11737-1-2012 Sterilization of medical products. Microbiological methods. Part 1. Evaluation of the microbial population on products.
References
1. Brook I. Secondary bacterial infections complicating skin lesions. Journal of Medical Microbiology. 2002;51(10): 808–12. https://doi.org/10.1099/0022-1317-51-10-808
2. Mancuso G, Midiri A, Gerace E, Biondo C. Bacterial antibiotic resistance: the most critical pathogens. Pathogens. 2021;10(10):1310. https://doi.org/10.3390/pathogens10101310
3. Odonkor S, Addo K. Bacteria resistance to antibiotics: recent trends and challenges. International Journal of Biological & Medical Research. 2011;2(4):1204–10.
4. Brooks B, Brooks A. Therapeutic strategies to combat antibiotic resistance. Advanced Drug Delivery Reviews. 2014;78:14–27. https://doi.org/10.1016/j.addr.2014.10.027
5. Fair R, Tor Y. Antibiotics and bacterial resistance in the 21st century. Perspectives in Medicinal Chemistry. 2014;6:S14459. https://doi.org/10.4137/PMC.S14459
6. Strateva T, Yordanov D. Pseudomonas aeruginosa–a phenomenon of bacterial resistance. Journal of Medical Microbiology. 2009; 58(9):1133–48. https://doi.org/10.1099/jmm.0.009142-0
7. Vestby L, Gronseth T, Simm R, Nesse L. Bacterial biofilm and its role in the pathogenesis of disease. Antibiotics. 2020;9(2):59. https://doi.org/10.3390/antibiotics9020059
8. Prakash B, Veeregowda B, Krishnappa G. Biofilms: a survival strategy of bacteria. Current science. 2003;85:1299–307.
9. Bi Y, Xia G, Shi C, Wan J, Liu L, Chen Y, et al. Therapeutic strategies against bacterial biofilms. Fundamental Research. 2021;1(2):193–212. https://doi.org/10.1016/j.fmre.2021.02.003
10. Singh B, Ghosh S, Chauhan A. Development, dynamics and control of antimicrobial-resistant bacterial biofilms: a review. Environmental Chemistry Letters. 2021;19:1983–93. https://doi.org/10.1007/s10311-020-01169-5
11. Geisinger E, Isberg R. Interplay Between Antibiotic Resistance and Virulence During Disease Promoted by Multidrug-Resistant Bacteria. Journal of Infectious Diseases. 2017;215(1):9–17. https://doi.org/10.1093/infdis/jiw402
12. Pay GV, Rakitina DV, Sukhina MA, Yudin SM, Makarov VV, Maniya TR, et al. Study of the relationship between antibiotic resistance markers and virulence markers in NDM-positive Klebsiella pneumoniae strains circulating in various waters and human loci. Environmental Hygiene. 2021;100(12):1366–71 (In Russ.).
13. Venezia R, Orrico M, Houston E, Yin S, Naumova Y. Lethal activity of nonthermal plasma sterilization against microorganisms. Infection Control & Hospital Epidemiology. 2008;29(5):430–6. https://doi.org/10.1086/588003
14. Laroussi M. Cold plasma in medicine and healthcare: The new frontier in low temperature plasma applications. Frontiers in Physics. 2020;8:74. https://doi.org/10.3389/fphy.2020.00074
15. Karthik C, Sarngadharan S, Thomas V. Low-Temperature Plasma Techniques in Biomedical Applications and Therapeutics: An Overview. International Journal of Molecular Sciences. 2023;25(1):524. https://doi.org/10.3390/ijms25010524
16. Mohamed H, Nayak G, Rendine N, Wigdahl B, Krebs F, Bruggeman P, et al. Non-thermal plasma as a novel strategy for treating or preventing viral infection and associated disease. Frontiers in Physics. 2021;9:683118. https://doi.org/10.3389/fphy.2021.683118
17. Perucca M. Introduction to plasma and plasma technology. Plasma Technology for Hyperfunctional Surfaces: Food, Biomedical, and Textile Applications. Wiley-VCH Verlag GmbH & Co;2010:1–32. https://doi.org/10.1002/9783527630455.ch1
18. Hury S, Vidal D, Desor F, Pelletier J, Lagarde T. A parametric study of the destruction efficiency of Bacillus spores in low pressure oxygen-based plasmas. Letters in Applied Microbiology.1998;26(6):417–21. https://doi.org/10.1046/j.1472-765x.1998.00365.x
19. Lassen K, Nordby B, Grün R. The dependence of the sporicidal effects on the power and pressure of RF-generated plasma processes. Journal of Biomedical Materials Research Part B: Applied Biomaterials. 2005;74(1):553–9. https://doi.org/10.1002/jbm.b.30239
20. Shimizu T, Steffes B, Pompl R, Jamitzky F, Bunk W, Ramrath K, et al. Characterization of microwave plasma torch for decontamination. Plasma Processes and Polymers. 2008;5(6):577–82.
21. Yan D, Malyavko A, Wang Q, Ostrikov K, Sherman J, Keidar M. Multi-modal biological destruction by cold atmospheric plasma: capability and mechanism. Biomedicines. 2021;9(9):1259. https://doi.org/10.3390/biomedicines9091259
22. Lackmann J, Bandow J. Inactivation of microbes and macromolecules by atmospheric-pressure plasma jets. Applied Microbiology and Biotechnology.2014;98:6205–13. https://doi.org/10.1007/s00253-014-5781-9
23. Raji A, Vasu D, Pandiyaraj K, Ghobeira R, De Geyter N, Morent R, et al. Combinatorial effects of non-thermal plasma oxidation processes and photocatalytic activity on the inactivation of bacteria and degradation of toxic compounds in wastewater. RSC Advances. 2022;12(22):14246–59. https://doi.org/10.1039/d1ra09337a
24. Moreau M, Orange N, Feuilloley M. Non-thermal plasma technologies: new tools for bio-decontamination. Biotechnology Advances. 2008;26(6):610–7. https://doi.org/10.1016/j.biotechadv.2008.08.001
25. Sung S, Huh J, Yun M, Chang B, Jeong C, Jeon Y. Sterilization effect of atmospheric pressure non-thermal air plasma on dental instruments. The Journal of Advanced Prosthodontics. 2013;5(1):2–8. https://doi.org/10.4047/jap.2013.5.1.2
26. Busco G, Robert E, Chettouh-Hammas N, Pouvesle J, Grillon C. The emerging potential of cold atmospheric plasma in skin biology. Free Radical Biology and Medicine. 2020;161:290–304. https://doi.org/10.1016/j.freeradbiomed.2020.10.004
27. Lotfi M, Khani M, Shokri B. A review of cold atmospheric plasma applications in dermatology and aesthetics. Plasma Medicine. 2023;13:1. https://doi.org/10.1615/PlasmaMed.2023049359
28. Frolov SA, Kuzminov AM, Vyshegorodtsev DV, Korolik VYu, Tuktagulov NV, Zharkov EE, et al. Low-temperature argon plasma in the wounds treatment after hemorrhoidectomy. Koloproktologia. 2021;20(3):51–61 (In Russ.). https://doi.org/10.33878/2073-7556-2021-20-3-51-61
29. Shulutko AM, Osmanov ÉG, Novikova IV, Chochiya SL, Seredin VP, Macharadze AD. Plasma management in complex treatment of late inflammatory complications after injection contour plasty with polyacrylamide gel. Surgery. Journal named by Pirogov NI. 2017;9:59–63. https://doi.org/10.17116/hirurgia2017959-63
30. Pierdzioch P, Hartwig S, Herbst S, Raguse J, Dommisch H, Abu-Sirhan S, et al. Cold plasma: a novel approach to treat infected dentin–a combined ex vivo and in vitro study. Clinical Oral Investigations. 2016;20:2429–35. https://doi.org/10.1007/s00784-016-1723-5
31. Herbst S, Hertel M, Ballout H, Pierdzioch P, Weltmann K, Wirtz H, et al. Bactericidal efficacy of cold plasma at different depths of infected root canals in vitro. The Open Dentistry Journal. 2015;9:486. https://doi.org/10.2174/1874210601509010486
32. Scholtz V, Vaňková E, Kašparová P, Premanath R, Karunasagar I, Julák J. Non-thermal plasma treatment of ESKAPE pathogens: a review. Frontiers in Microbiology. 2021;12:737635. https://doi.org/10.3389/fmicb.2021.737635
33. Flynn P, Higginbotham S, Alshraiedeh N, Gorman S, Graham W, Gilmore B. Bactericidal efficacy of atmospheric pressure non-thermal plasma (APNTP) against the ESKAPE pathogens. International Journal of Antimicrobial Agents. 2015;46:101–7. https://doi.org/10.1016/j.ijantimicag.2015.02.026
34. Soušková H, Scholtz V, Julák J, Kommová L, Savická D, Pazlarová J. The survival of micromycetes and yeasts under the low-temperature plasma generated in electrical discharge. Folia Microbiologica. 2011;56:77–9. https://doi.org/10.1007/s12223-011-0005-5
35. Veerana M, Ketya W, Park G. Application of non-thermal plasma to fungal resources. Journal of Fungi. 2022,8(2):102. https://doi.org/10.3390/jof8020102
36. Tyczkowska-Sieroń E, Kałużewski T, Grabiec M, Kałużewski B, Tyczkowski J. Genotypic and phenotypic changes in Candida albicans as a result of cold plasma treatment. International Journal of Molecule Science. 2020;21:8100. https://doi.org/10.3390/ijms21218100
37.
About the Authors
A. V. ZagainovaRussian Federation
Anzhelika V. Zagainova, Cand. Sci. (Biol.)
Moscow
M. A. Sukhina
Russian Federation
Marina A. Sukhina, Cand. Sci. (Biol.)
Moscow
A. B. Zemlianoi
Russian Federation
Alexander B. Zemlianoi, Dr. Sci. (Med.)
Krasnogorsk
Moscow
T. A. Zelenina
Russian Federation
Tatiana A. Zelenina, Cand. Sci. (Med.)
St. Petersburg
P. S. Markevich
Russian Federation
Pavel S. Markevich, Cand. Sci. (Med.)
Krasnogorsk
K. A. Novozhilov
Russian Federation
Konstantin A. Novozhilov, Cand. Sci. (Med.)
Moscow
Z. E. Fedets
Russian Federation
Zlata E. Fedets
Moscow
M. N. Pankova
Russian Federation
Marina N. Pankova
Moscow
T. R. Maniya
Russian Federation
Tamari R. Maniya
Moscow
O. V. Gritsyuk
Russian Federation
Olga V. Gritsyuk, Cand. Sci. (Biol.)
Moscow
Supplementary files
Review
For citations:
Zagainova A.V., Sukhina M.A., Zemlianoi A.B., Zelenina T.A., Markevich P.S., Novozhilov K.A., Fedets Z.E., Pankova M.N., Maniya T.R., Gritsyuk O.V. Antimicrobial effect of low-temperature argon plasma on surgical infection in vitro. Extreme Medicine. 2025;27(3):351-366. https://doi.org/10.47183/mes.2025-332









